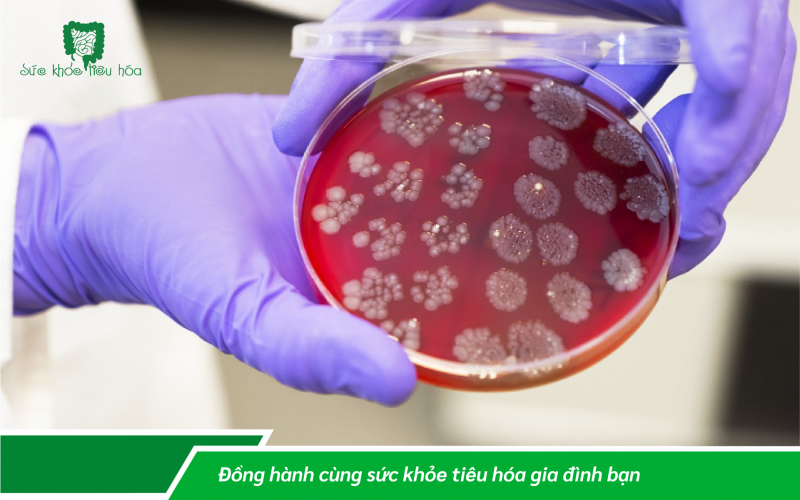
HỆ VI SINH CẢI THIỆN SỨC KHỎE BẠN NHƯ THẾ NÀO?

HỆ VI SINH CẢI THIỆN SỨC KHỎE BẠN NHƯ THẾ NÀO?
Ngày 19/09/2022
Vào tháng 5 năm 2012, Amanda Kabage, khi đó 32 tuổi, là một nhà nghiên cứu nhi khoa tại Đại học Minnesota, bắt đầu gặp các vấn đề bất thường về đường tiêu hóa.
Cô ấy bị hơn mười lần đi tiêu mỗi ngày và thấy có một lượng máu đáng lo ngại trong phân. Đối với các bác sĩ, tình trạng này giống như một bệnh nhiễm trùng ruột do vi khuẩn và cô ấy đã được kê hai loại thuốc kháng sinh khác nhau.
Nhiều tháng trôi qua và các triệu chứng xấu đi. Cô ấy vốn là một phụ nữ trẻ khỏe mạnh, nhưng đột nhiên bị đau bụng kinh niên, khiến cô ấy bỏ thức ăn cứng và giảm 9 kg. Tóc rụng thành từng chùm và việc cô nghỉ làm bắt đầu bị đồng nghiệp chú ý. Cô ấy đã được kê một số loại thuốc nhưng vô ích.
BỆNH NHIỄM TRÙNG RUỘT DO CLOSTRIDIUM DIFFICILE
Vào tháng 11 cùng năm, cô ấy được chẩn đoán mắc bệnh nhiễm trùng do vi khuẩn có tên là Clostridium difficile, viết tắt là C. diff. Mặc dù vi khuẩn này được tìm thấy trong ruột của hầu hết mọi người, nhưng nếu nó phát triển ngoài tầm kiểm soát, nó có thể giải phóng chất độc làm hỏng ruột và giết chết các vi khuẩn tốt khác bảo đảm cho cơ quan hoạt động. Nhiễm trùng thường xảy ra do dùng thuốc kháng sinh mạnh, làm gián đoạn hệ vi sinh đường ruột khỏe mạnh.
Vi khuẩn Clostridium difficile
LIỆU PHÁP CẤY GHÉP HỆ VI SINH VẬT

Vì không có phương pháp điều trị nào làm giảm cơn đau, cô Kabage đã sử dụng các kỹ năng nghiên cứu của mình. Cô ấy đọc các bài báo khoa học, rồi đích thân liên lạc với một nhà nghiên cứu C. difficile nổi tiếng để hỏi xem liệu cô ấy có thể tham gia một liệu pháp thử nghiệm mà họ đang thực hiện liên quan đến việc cấy vi khuẩn đường ruột từ một người khỏe mạnh vào người bệnh.
Vào đầu tháng 9 năm 2013, Kabage đã trải qua quy trình được gọi là cấy ghép hệ vi sinh vật trong phân, hay TMF (TRANSPLANTATION DE MICROBIOTE FÉCAL) Phân của một người hiến tặng có chứa một hỗn hợp vi khuẩn lành mạnh đã được cấy vào ruột của Kabage để thay thế hệ vi sinh vật bị hư hỏng của cô ấy.
Kabage nói: “Đêm hôm đó, ruột của tôi rất náo động, cứ như thể những con vi trùng mới của tôi đang tìm thấy ngôi nhà mới của chúng và tự sinh sống trong ruột già của tôi”. Kết quả nhanh chóng và bất ngờ. Sau 14 tháng chịu đựng đau khổ vì căn bệnh, hai tuần sau khi điều trị Kabage đã trở lại bình thường. Các vấn đề về đường tiêu hóa của cô đã hoàn toàn biến mất.
Phương pháp điều trị mà cô ấy nhận được là đỉnh cao của kiến thức mới ngày càng tăng rằng các vi sinh vật sống trong cơ thể chúng ta đóng một vai trò quan trọng, dù rằng bị đánh giá thấp, đối với sức khỏe của chúng ta. Nghiên cứu khoa học đã khám phá ra những tương tác phức tạp giữa sức khỏe tổng thể của chúng ta và hệ thực vật phát triển mạnh trong miệng, mũi, đường thở, phổi, dạ dày, ruột kết, cơ quan sinh dục và da. Chúng giúp chúng ta tiêu hóa, trao đổi chất, sản xuất chất nhầy, bôi trơn và là tuyến phòng thủ đầu tiên chống lại các sinh vật lạ có thể gây hại cho chúng ta.
Chúng ta ngày càng hiểu rõ mối quan hệ phức tạp suốt đời này, chúng ta càng có thể sử dụng nó cho lợi ích của mình. Nhiều chuyên gia hy vọng rằng chúng ta sẽ sớm bước vào buổi bình minh của kỷ nguyên chăm sóc sức khỏe mới, sẽ cho phép chăm sóc và cải thiện những vi khuẩn sống chung vì lợi ích của chính chúng ta
KỶ NGUYÊN CỦA HỆ VI SINH TRONG CHĂM SÓC SỨC KHỎE
Tốt nhất nên nghĩ về hệ vi sinh vật như một thành phố của các cộng đồng. Nó được tạo thành từ hàng nghìn tỷ vi khuẩn, nấm và vi rút lân cận, tất cả đều chen lấn để giành lấy không gian bên trong và trên bề mặt cơ thể chúng ta. Chúng sống tồn tại trong khu vực riêng của chúng, chúng cũng đóng những vai trò có lợi cho toàn bộ cơ thể. Một hệ vi sinh vật khỏe mạnh là một hệ vi sinh vật phong phú và đa dạng, và mọi thứ từ chế độ ăn uống đến môi trường của chúng ta đều ảnh hưởng đến cách nó hoạt động.
Nhưng việc lạm dụng quá nhiều thuốc kháng sinh và tiêu thụ thực phẩm chế biến quá kỹ, đang tiêu diệt hệ vi sinh vật đường ruột của chúng ta, khiến mọi người dễ bị nhiễm trùng hơn như C. difficile và các dạng bệnh khác. Tầm quan trọng chính xác của mối quan hệ này giữa các vi sinh vật và sức khỏe của chúng ta ngày càng trở nên rõ ràng.
Có lẽ bước quan trọng nhất là nhận ra rằng chúng ta cũng có thể sử dụng hệ vi sinh vật của mình để giúp điều trị và thậm chí ngăn ngừa bệnh tật. Sự xuất hiện của các chủng vi khuẩn C. difficile siêu kháng đã dẫn đến sự gia tăng đáng kể số ca mắc bệnh trong hơn 20 năm qua và hơn 20% số ca hiện nay liên quan đến vi khuẩn đã trở nên kháng thuốc kháng sinh. Điều này có nghĩa là cách tiếp cận hiện nay của chúng ta để chống lại những bệnh nhiễm trùng này - bằng cách điều trị bằng thuốc kháng sinh - ngày càng trở nên giảm hiệu quả do kháng kháng sinh. Những loại có hiệu quả được sử dụng một cách tiết kiệm vì sợ gây ra sự kháng thuốc đối với chúng.
Nhưng TMF cung cấp một giải pháp thay thế trong cuộc chiến chống lại các bệnh nhiễm trùng như C. difficile. Bằng cách khôi phục sự cân bằng lành mạnh của các vi khuẩn đường ruột, nó cho phép những vi khuẩn này kiểm soát số lượng C. Difficile.

Alexander Khoruts, giám đốc y khoa của Chương trình trị liệu vi sinh vật của Đại học Minnesota và là người tiên phong trong lĩnh vực TMF cho biết: “Có thể nói rằng thập kỷ qua là thập kỷ xuất hiện TMF trong thực hành lâm sàng. Chúng ta hiện đang bước sang một chương mới nghiêm túc hơn về mặt phát triển sản phẩm. FMT này về cơ bản chỉ là một chương trong những gì có thể là một câu chuyện sẽ tiếp tục đi đến toàn bộ biên giới của liệu pháp điều trị y tế.”
AustrapharmVN
Nguồn tham khảo: BIOLOGIE HUMAINE : COMMENT VOTRE MICROBIOME PEUT AMÉLIORER VOTRE SANTÉ
Bài viết liên quan
